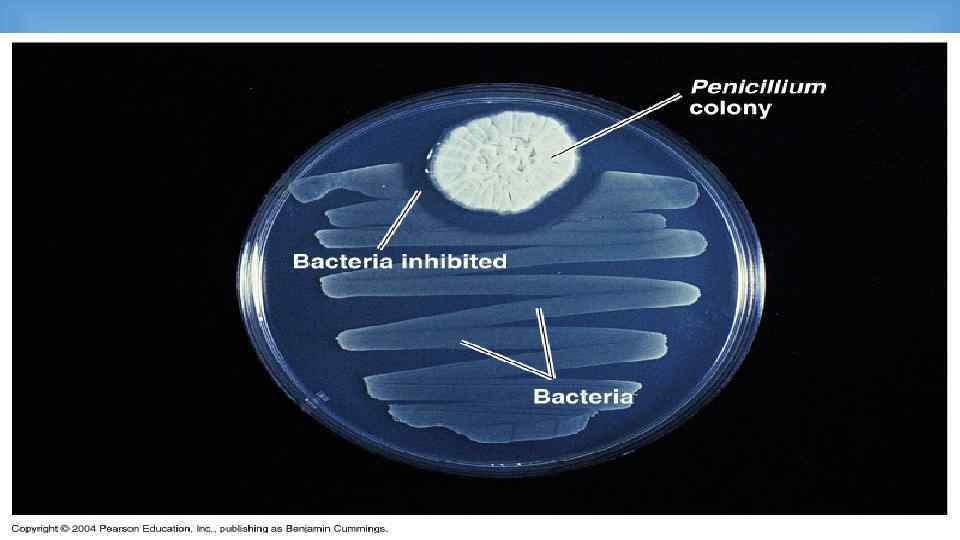
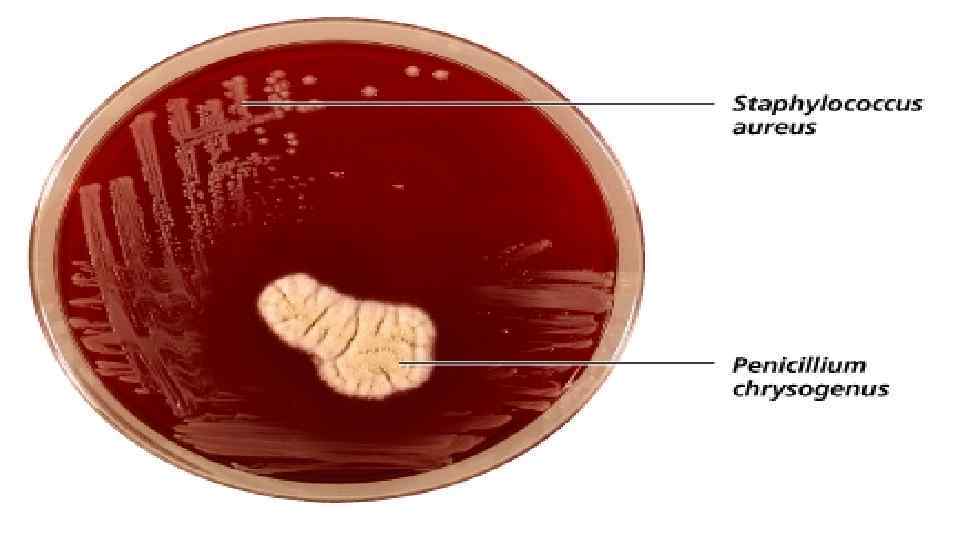
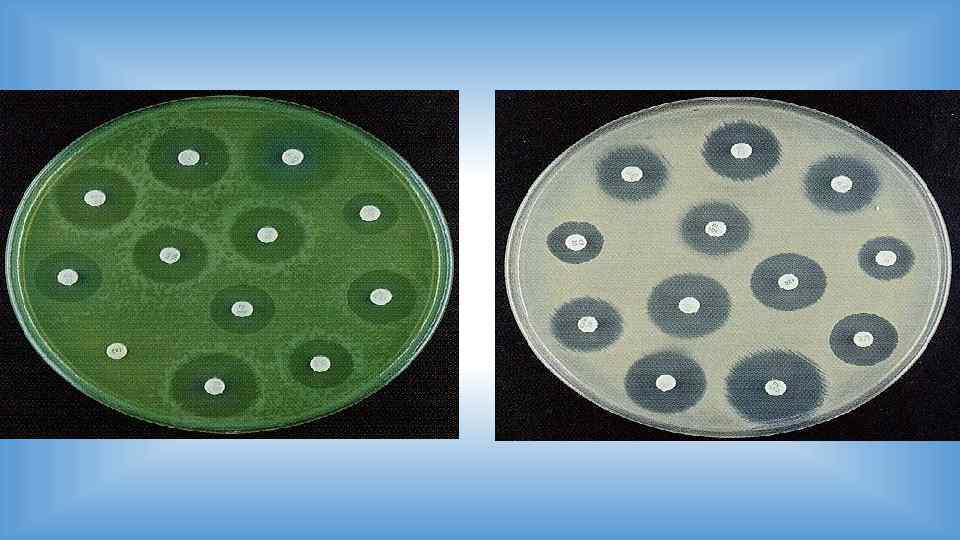
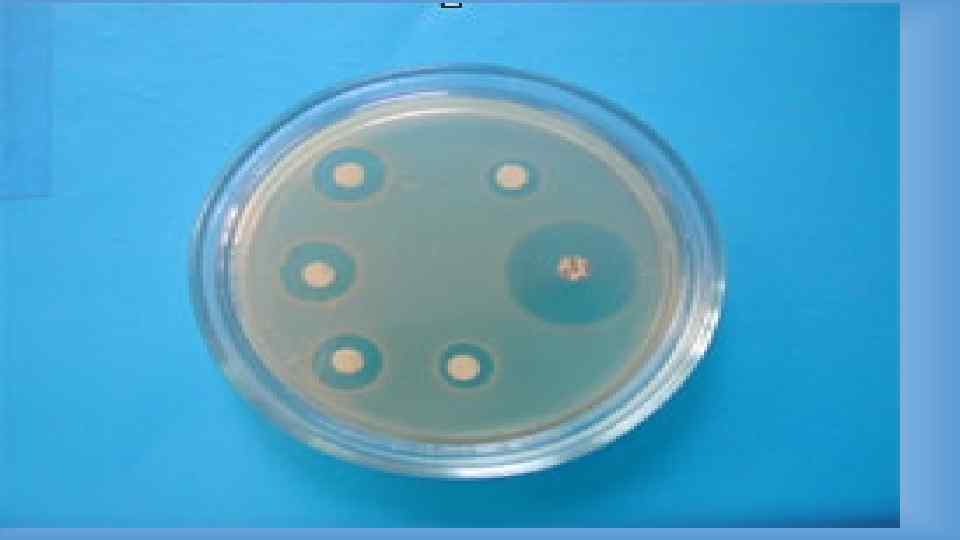
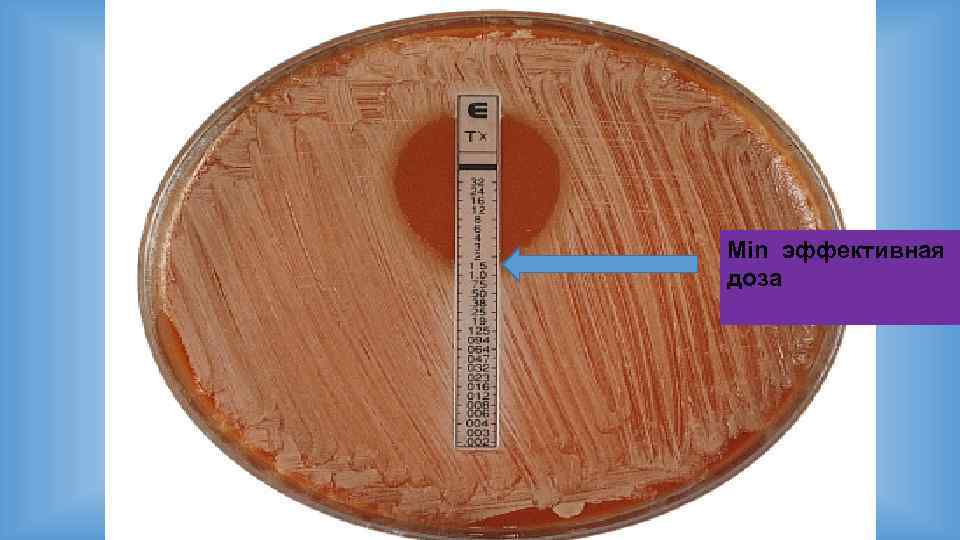
Min эффективная доза
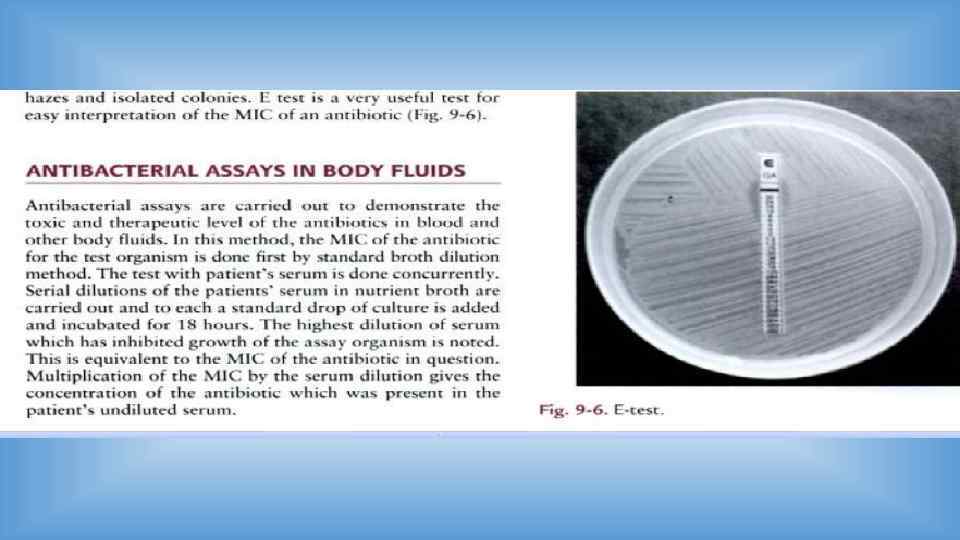

2-Антибиотики.pptx
- Количество слайдов: 162

АНТИБИОТИКИ Рисунки для презентаций (Ссылка: Internet < 2008 г. )

Антибиотики (презентации ин. ) • • http: //www. slideshare. net/bmudallal/antibiotics-40836218 http: //www. slideshare. net/astralfilledsky/antibiotics-ppt http: //www. slideshare. net/mokjos 64/antibiotic-principles? related=1 http: //www. slideshare. net/surgeonjaved/basic-principles-of-antimicrobial-therapy? related=1 (базисные принципы) • http: //www. slideshare. net/nclexvideos/pharmacology-antibiotics? related=1 (фармакология) • http: //www. slideshare. net/mokjos 64/antibiotic-principles? related=2 (принципы) • http: //www. slideshare. net/madhu 56799/antibiotic-resistancemadhuri-rudraraju? related=3 (резистентность) • http: //www. slideshare. net/specialclass/antibiotics-2173921? related=1 • http: //www. slideshare. net/sulavmetal/antibiotic-resistance (резистентность)

Антибиотики (Киров) • http: //vmede. org/sait/? page=29&id=Farmakologija_klin_farm_y 4 ebn ik_kykes_2009&menu=Farmakologija_klin_farm_y 4 ebnik_kykes_200 9

Антибио тики (от др. -греч. anti — против, bios — жизнь) — вещества природного или полусинтетического происхождения, подавляющие рост живых клеток, чаще всего прокариотических или простейших.

Антимикробные препараты - лекарственные препараты природного или искусственного происхождения, обладающие избирательной активностью в отношении микроорганизмов (бактерий, вирусов, грибов, простейших)

• Антибиотик — вещество микробного, животного или растительного происхождения, способное подавлять рост микроорганизмов или вызывать их гибель. • АНТИБИОТИКИ - вещества, синтезируемые микроорганизмами, и продукты хим. модификации этих в-в, избирательно подавляющие рост патогенных микроорганизмов, низших грибов, а также некоторых вирусов и клеток злокачественных новообразований.

Цель антимикробной терапии • Эрадикация (элиминация) возбудителей инфекционного заболевания • • • Предотвращение перехода острой инфекции в хроническую Снижение частоты рецидивов при хронических заболеваниях Увеличение длительности периода ремиссии при хронических заболеваниях

Описано более 6 тыс. природных антибиотиков, однако широко применяются только около 50. Резервные антибиотики.

Классификация антимикробных препаратов • По типу действия - бактериостатические - бактерицидные, в т. ч. бактериолитические (лизирующие клетку) • По спектру действия * широкого (действуют на широкий круг микробов) * узкого (действуют только на Гр+ микрофлору …) - антибактериальные -- противотуберкулезные - противовирусные - противогрибковые - противопротозойные, противогельминтные

• По механизму действия - тормозящие - синтез наружной клеточной стенки - функции ЦПМ - синтез белка - синтез НК (нуклеиновых кислот) - метаболизм микробной клетки


История


Годы открытия главных а/б


Apothekenschaufenster 1954

Основные продуценты антибиотиков (= а/б) - почвенные микроорганизмы - актиномицеты, плесневые грибы и бактерии.

Streptomyces Growth and limited spore production of NRRL 30562 on carnation leaves. (b) Growth of Streptomyces NRRL 30562 on autoclaved twig pieces of its natural host, K. nigriscans. Note the proliferation of numerous mycelia bearing chains of spores. Bars, 1 µm.

Streptomyces coelicolor A 3(2) producing Colonies of droplets of the blue-pigmented antibiotic actinorhodin. Капелька садится на поверхность колоний за счет гидрофобной природы (надсудсубстратных) гиф и спор. The droplets sit on the surface of the colonies due to the hydrophobic nature of the aerial hyphae and spores. The production of antibiotics and the developmental cycle of S. coelicolor is complex and its regulation in part is governed by the actions of two-component signal transduction pathways.

Огромное разнообразие антибиотиков и видов их воздействия на организм человека явилось причиной классифицирования и разделения антибиотиков на группы. По характеру воздействия на бактериальную клетку антибиотики можно разделить на три группы: • бактериостатические (бактерии живы, но не в состоянии размножаться), • бактерициды (бактерии умертвляются, но физически продолжают присутствовать в среде), • бактериолитические (бактерии умертвляются, и бактериальные клеточные стенки разрушаются). http: //ru. wikipedia. org/wiki/%D 0%90%D 0%BD%D 1%82%D 0%B 8%D 0%B 1%D 0%B 8%D 0%BE %D 1%82%D 0%B 8%D 0%BA%D 0%B 8

Фармакодинамика


Фармакокинетика природных пенициллинов Параметр Бензилпенициллин Феноксиметилпеници ллин Прокаинпенициллин Бензатинпенициллин 20 40 - 60 - - Влияние пищи на всасываемость - нет - - Связь с белками, % 60 78 почки Т 1/2: КК в норме 0, 5 часа 1 час КК < 10 мл 10 часов 4 часа Всасывание в ЖКТ, % Выведение в минуту

Сравнительная характеристика ампициллина и амоксициллина Критерии Ампициллин Амоксициллин Пневмококков +++ Сальмонелл +++ Шигелл +++++ + H. pylory + +++ Пути введения Внутрь, в/м, в/в Внутрь Биодоступность приеме внутрь 40 % 90 % Влияние пищи на биодоступность ↓ в 2 раза Не влияет Уровень в мокроте Низкий Высокий Уровень в моче Низкий Высокий Активность против:

http: //www. slideshare. net/gurustip/defense-against-infectious-disease-core -presentation

Киллинг бактерий пенициллином

Другие области применения • Доксициклин и миноциклин, помимо их основных антибактериальных свойств, оказывают противовоспалительное действие при ревматоидном артрите и являются ингибиторами матриксных металлопротеиназ. • Описано иммуномодулирующее (иммуносупрессивное или иммуностимулирующее) действие некоторых других антибиотиков. • Известны противоопухолевые антибиотики. http: //ru. wikipedia. org/wiki/%D 0%90%D 0%BD%D 1%82%D 0%B 8%D 0%B 1%D 0%B 8%D 0%BE %D 1%82%D 0%B 8%D 0%BA%D 0%B 8

Внутриклеточные а/б


Побочные действия • ИД (= иммунодефицит) • Дисбиозы • Токсичность /нефро-, гепато-, нейротоксичность/, угнетение ККМ. • Аллергии (у 1% лиц аллергия на пенициллины)

• Аминогликозиды и ванкомицин могут вызвать поражение слухового или вестибулярного аппарата. • Гр- Эндотоксический шок • Рифампицин Нейтропения • Геморрагический синдром (вызывают цефалоспорины второго-третьего поколения)

• Существует реестр препаратов, которые могут быть прописаны во время беременности, но есть и такие, которые нельзя принимать в этот период ни в коем случае. Например, фторхинолоны влияют на рост костной системы ребенка и в дальнейшем становятся причиной всевозможных патологий. • Препараты тетрациклиновой группы окрашивают зубы ребенка в черный цвет.


Взаимодействие с алкоголем Алкоголь может влиять как на активность, так и на метаболизм антибиотиков, влияя на активность ферментов печени, расщепляющих антибиотики. В частности, некоторые антибиотики, включая метронидазол, тинидазол, ко-тримоксазол, цефамандол, кетоконазол, латамоксеф, цефоперазон, амоксициллин, цефменоксим и фуразолидон химически взаимодействуют с алкоголем, что приводит к серьёзным побочным эффектам, включающим тошноту, рвоту, одышку и даже смерть. Употребление алкоголя с этими антибиотиками категорически противопоказано. Кроме того, концентрация доксициклина и эритромицина может быть, при определённых обстоятельствах, существенно снижена при употреблении алкоголя. http: //ru. wikipedia. org/wiki/%D 0%90%D 0%BD%D 1%82%D 0%B 8%D 0%B 1%D 0%B 8%D 0%BE %D 1%82%D 0%B 8%D 0%BA%D 0%B 8

Реакция Яриша-Герксгеймера - Аллергическая-? реакция которая возникает в первые сутки после начала лечения специфическими антибактериальными средствами больных спирохетозами, связана с быстрым высвобождением большого количества спирохетозных антигенов. Проявляется повышением температуры, ознобом, снижением артериального давления, тахикардией, тошнотой, головной болью, болью в мышцах, усугублением существовавших или появлением новых симптомов основного заболевания.



Оценка чувствительности к а/б 1) 2) 3) 4) Раститровкой Наложения дисков Е-тест Прибором

Оценка чувствительности к а/б 1) 2) 3) 4) Раститровкой Наложения дисков Е-тест Прибором

1) Метод титрования антибиотика Раститровка по питательной среде; + капля микробов 37 градусов ночь (~ 8 -12 часов) Контроль

МПК (минимальная подавляющая концентрация) а/б

Минимальная подавляющая концентрация




Оценка чувствительности к а/б 1) 2) 3) 4) Раститровкой Наложения дисков (диффузный метод) Е-тест Прибором

2) Метод наложения бумажных дисков (диффузный метод) Посев газоном микробов Наложение дисков, пропитанных антибиотиками 37 градусов на ночь

• R • S • Proteus 15 R




ОПРЕДЕЛЕНИЕ ЧУВСТВИТЕЛЬНОСТИ БАКТЕРИЙ К АНТИБИОТИКАМ МЕТОД ДИСКОВ Бактериальную культуру засевают газоном на питательный агар, после чего на его поверхность пинцетом помещают на равномерном расстоянии друг от друга бумажные диски, содержащие определенные дозы разных антибиотиков. Посевы инкубируют при 37 0 С в течение суток. По диаметру зон задержки роста культуры судят о ее чувствительности к соответствующим антибиотикам. При зоне задержки роста до 15 мм культура расценивается как нечувствительная или низко чувствительная, 15 – 24 мм – средняя чувствительность, 25 мм и более – высокочувствительная. http: //microbiologygpma. narod. ru/sreda. html

Оценка чувствительности к а/б 1) 2) 3) 4) Раститровкой Наложения дисков Е-тест Прибором

Е-тест

Е-тест

Антибиотикограмма

Min эффективная доза

Оценка чувствительности к а/б 1) 2) 3) 4) Раститровкой Наложения дисков Е-тест Прибором





Принципы рациональной антибиотикотерапии Идеал: выделить возбудитель и определить чувствительность к а/б Ø Выбор: Ø l l С учетом возраста С учетом побочных эффектов, особенно при комбинации антибиотиков Менее токсичный Узкого спектра действия Не должно быть в свободной продаже Ø Комбинировать с другими препаратами (прополис …) Ø

Принципы рациональной антибиотикотерапии • «Не стрелять пушкой по воробьям. » • Новорожденных лечить гомеопатическими препаратами (мягкими препаратами) • Патогенный – УПМ • Если патоген – УПМ, то убиваем не до конца, а лишь затормаживаем размножения • Если чумная палочка, то убиваем до последнего микроба • + Местное применение при патологии СО • Рифампицином не лечить (только для фтизиаторов)

Принципы рациональной антибиотикотерапии • Эффект накопления а/б • А/б 1 -2 -3 -4 -5 поколений. Резервные а/б. • Производить смену антибиотиков • Метаболайзеры (быстрые, медленные) Быстрому метаболайзеру назначать большие дозы а/б • ГЭБ Доза большая • Фармакокинетика • Период полувыведения а/б • Способ введения

• • • Принципы рациональной антибиотикотерапии С/х животные лечить другими антибиотиками в почву … Первую неделю оставить для ИО С учетом возможных осложнений Противовирусные антибиотики L-формы бактерий

• Повторное зб Антибиотик другой группы

Классификации а/б • Широкого и узкого спектра действия • Бактерицидные – бактериостатические • По действию на ряд м/о • По механизму действия • По химической структуре • …


Классификации а/б • Широкого и узкого спектра действия • Бактерицидные – бактериостатические • По действию на ряд м/о • По механизму действия • По химической структуре • …



Классификации а/б • Широкого и узкого спектра действия • Бактерицидные – бактериостатические • По действию на ряд м/о • По механизму действия • По химической структуре • …

Механизмы действия а/б 1. 2. 3. 4. 5. 6. 7. Подавление синтеза клеточной стенки Подавление функционирования ЦПМ Подавление синтеза белка Подавление синтеза НК Торможение синтеза фолиевой кислоты Подавление дыхательной цепи …





Механизмы действия а/б 1. 2. 3. 4. 5. 6. 7. Подавление синтеза клеточной стенки Подавление функционирования ЦПМ Подавление синтеза белка Подавление синтеза НК Торможение синтеза фолиевой кислоты Подавление дыхательной цепи …


Механизмы биологического действия Ø Нарушение синтеза клеточной стенки посредством -- ингибирования синтеза пептидогликана (пенициллин, цефалоспорин, монобактамы), -- образования димеров и их переноса к растущим цепям пептидогликана (ванкомицин, флавомицин) или -- синтеза хитина (никкомицин, туникамицин). Обладают бактерицидным действием, не убивают покоящиеся клетки и клетки, лишенные клеточной стенки. http: //ru. wikipedia. org/wiki/%D 0%90%D 0%BD%D 1%82%D 0%B 8%D 0%B 1%D 0%B 8%D 0%BE %D 1%82%D 0%B 8%D 0%BA%D 0%B 8

По молекулярному механизму действия 1)ингибиторы синтеза клеточной стенки м/о (пенициллины, циклосерин и др. ) http: //www. xumuk. ru/encyklopedia/306. html


Механизмы действия а/б 1. 2. 3. 4. 5. 6. 7. Подавление синтеза клеточной стенки Подавление функционирования ЦПМ Подавление синтеза белка Подавление синтеза НК Торможение синтеза фолиевой кислоты Подавление дыхательной цепи …

ü Нарушение функционирования мембран: нарушение целостности мембраны, l образование ионных каналов, l связывание ионов в комплексы, l растворимые в липидах, l их транспортировка. l Подобным образом действуют v нистатин v грамицидины, v полимиксины. http: //ru. wikipedia. org/wiki/%D 0%90%D 0%BD%D 1%82%D 0%B 8%D 0%B 1%D 0%B 8%D 0%BE %D 1%82%D 0%B 8%D 0%BA%D 0%B 8




Ингибиторы функций мембран и обладающие детергентными свойствами (полиены, новобиоцин и др. ) http: //www. xumuk. ru/encyklopedia/306. html

Антигрибковое действие препаратов

Механизмы действия а/б 1. 2. 3. 4. 5. 6. 7. Подавление синтеза клеточной стенки Подавление функционирования ЦПМ Подавление синтеза белка Подавление синтеза НК Торможение синтеза фолиевой кислоты Подавление дыхательной цепи …

Ингибиторы синтеза белка и функций рибосом - тетрациклины, макролиды … http: //www. xumuk. ru/encyklopedia/306. html

Ø Нарушение синтеза белка ингибирование активации и переноса аминокислот, • функций рибосом (стрептомицин, тетрациклин, пуромицин). • http: //ru. wikipedia. org/wiki/%D 0%90%D 0%BD%D 1%82%D 0%B 8%D 0%B 1%D 0%B 8%D 0%BE %D 1%82%D 0%B 8%D 0%BA%D 0%B 8







Механизмы действия а/б

Ribosomes - protein synthesis • Eukaryotic Ribosomes • Prokaryotic Ribosome • 70 S • 50 S • 30 S • 80 S • 60 S • 40 S

Бактериальные рибосомы

Antibiotics that act at the level of protein synthesis initiation

Antibiotics that act at the level of the elongation phase of protein synthesis

Механизмы действия а/б 1. 2. 3. 4. 5. 6. 7. Подавление синтеза клеточной стенки Подавление функционирования ЦПМ Подавление синтеза белка Подавление синтеза НК Торможение синтеза фолиевой кислоты Подавление дыхательной цепи …




Ø Подавление синтеза нуклеиновых кислот: связывание с ДНК и препятствование продвижению РНК-полимеразы (актидин), l сшивание цепей ДНК, что вызывает невозможность её расплетания (рубомицин), l ингибирование ферментов. l Ø Нарушение синтеза пуринов и пиримидинов (азасерин, саркомицин). http: //ru. wikipedia. org/wiki/%D 0%90%D 0%BD%D 1%82%D 0%B 8%D 0%B 1%D 0%B 8%D 0%BE %D 1%82%D 0%B 8%D 0%BA%D 0%B 8

4) ингибиторы НК РНК (актиномицины, антрациклины) • ДНК (митомицин С, стрептонигрин). • http: //www. xumuk. ru/encyklopedia/306. html

Механизмы действия а/б 1. 2. 3. 4. 5. 6. 7. Подавление синтеза клеточной стенки Подавление функционирования ЦПМ Подавление синтеза белка Подавление синтеза НК Торможение синтеза фолиевой кислоты Подавление дыхательной цепи …







Механизмы действия а/б 1. 2. 3. 4. 5. 6. 7. Подавление синтеза клеточной стенки Подавление функционирования ЦПМ Подавление синтеза белка Подавление синтеза НК Торможение синтеза фолиевой кислоты Подавление дыхательной цепи …

Ø Торможение работы дыхательных ферментов (антимицины, олигомицины, ауровертин). http: //ru. wikipedia. org/wiki/%D 0%90%D 0%BD%D 1%82%D 0%B 8%D 0%B 1%D 0%B 8%D 0%BE %D 1%82%D 0%B 8%D 0%BA%D 0%B 8


Классификации а/б • Широкого и узкого спектра действия • Бактерицидные – бактериостатические • По действию на ряд м/о • По механизму действия • По химической структуре • …




По направленности (спектру) действия • 1) активные в отношении грамположит. микроорганизмов - макролидные антибиотики, линкомицин, фузидин и др. ; • 2) широкого спектра действия, т. е. активные в отношении как грамположительных, так и грамотрицат. микроорганизмов, - тетрациклины, аминогликозиды и др. ; • 3) противотуберкулезные - стрептомицин, канамицин, рифампицин, циклосерин и др. ; • 4) противогрибковые - гл. обр. полиены, напр. нистатин, леворин, гризеофульвин; все они действуют на цитоплазматич. мембрану патогенных грибов; http: //www. xumuk. ru/encyklopedia/306. html

• 5) активные в отношении простейших -трихомицин, паромомицин; • 6) противоопухолевые - актиномицины, антрациклины, блеомицины; ингибируют синтез нуклеиновых к-т; как правило, применяются в комплексе с др. препаратами (в т. ч. гормональными) наряду с лучевой терапией и оперативным лечением. • Ряд антибиотиков, в частности производные рифамицина, обладают противовирусной активностью, но не используются при лечении заболеваний вирусной этиологии. http: //www. xumuk. ru/encyklopedia/306. html



Рекомендуемая длительность а/б - терапии • Острый стрептококковый тонзиллит – 10 дней (азитромицин 5 дней) • Острый средний отит – 7 дней • Острый синусит – 10 – 14 дней • Обострение хронического бронхита – 7 – 10 дней (показана эффективность 5 -тидневных курсов респираторных ФХ) • Пневмония – 5 – 7 дней, при тяжелой ВБП с неуточненной этиологией – 10 дней, атипичные возбудители – 14 дней, стафилококки или Г- энтеробактерии – до 14 – 21 дня.

Противогрибковые препараты Пркпараты Описание и принцип действия Клинические проявления Резистентность Полиены Ассоциируют с молекулами ол Спектр действия: Грибы Пути введения: Амфотерицин В: IV. нистатин: актуальные нет Побочные эффекты: чихание, рвота, лихорадка Представители эргостерол Амфотерицин В; Нистатин Спектр действия: Грибы, G+ бактерий нет и паразитических простейших образует поры через грибковую мембрану, что приводит к утечке необходимых ионов из клетки. Пути введения: актуальные, IV Slreplomyces nodosus производит В амфотерицин действие за счет ингибирования Побочные эффекты: возможно, вызывает рак у людей

Препараты Описание и принцип действия Клинические проявления Сопротивляемость Тяжелые металлы (Hg, As, Сr, Sb) Представители: Отключает ферменты, разбив водородные связи необходимые для эффективной третичной структуры; препараты, содержащие мышьяк были первыми признан химиотерапевтическими средствами, которые были избирательно токсичны. Спектр действия: Метаболически активные клетки Пути введения: Местно, перорально Побочные эффекты: Токсичный для активных клеток, например, головного мозга, почек. печень и костный мозг нет Природные и полусинтетические препараты, полученные из коры дерева dnchona: ингибирует синтез ДНК паразитов малярии Спектр действия: Plasmodium Пути введения: орально Побочные эффекты: аллергические реакции. клетки нарушения зрения наличие хининовых насосов, которые удаляют препарат из клетки Синтетический препарат; впервые изготовлен в качестве красителя; является аналогом PABA, что необратимо связывается с ферментом, который производится фолиевой кислотой; синергетический с триметопримом Спектр действия: Широкий: эффективны против G+ и G-бактерий и некоторых простейших и грибов клетки, однако, сопротивление широко распространена Пути введения: орально Побочные эффекты: Редко: аллергические реакции, анемия, желтуха, задержкой умственного развития плода, если вводить в последнем триместре беременности Клетки которые требуют фолиевой кислоты в виде витаминных , также обладают естественной устойчивостью; к хромосомным мутациям, в результате чего снижен сродство к наркотикам Сальварсан Глюконовая Сурьма натрия Хинины Представители: Природный хинин Полусинтетические хинин: Хлорохина Примахинин Сульфонамиды

Препараты Описание и принцип действия Клинические проявления Сопротивляемость Триметоприм Блокирует второй метаболический шаг в формировании фолиевой кислоты с ПАБК, синергетический с сульфонамидами Спектр действия: Широкий: эффективны против G+ и G-бактерий и некоторых простейших и грибов, однако сопротивления широко распространено Клетки которые требуют фолиевой кислоты в качестве натурального витамина , частота хромосомных мутаций в результате снижена , сродство к наркотикам Пути введения: Oral Побочные эффекты: аллергические реакции у некоторых пациентов Nhroimidazoles Способ действия неизвестен Спектр действия: трихомонады, None Gtardia и Entamoeba Пути введения: Oral Побочные эффекты: метронидазол предполагается, вызывают рак нет

Противогельминтные препараты Препараты Описание и принцип действия Клинические проявления Сопротивляемос ть мебендазол Препараты-видимо ингибируют ферменты и некоторые функции микротрубочек, таким образом предотвращая цитокинезу и сегрегации хромосом во время митоза Спектр действия: Гельминты, Горди (простейшие) Пути введения: Oral Побочные эффекты: Нет нет Thiabendazole Привязка к рецепторам нейромедиаторов, в результате чего полное мышечное сокращение гельминтов Спектр действия: нематоды Пути введения: Oral Побочные эффекты: Нет нет Пирантела памоат Привлекает ионы кальция, которые необходимы для мышечного сокращения, стимулирует полное мышечное сокращение в гельминтов Спектр действия: цестоды, трематоды Пути введения: Oral Побочные эффекты: Нет нет


+ антивирусное действие ряда а/б



Antiviral drugs Препараты Описание и принцип действия Клинические проявления Сопротивляемост ь Арилдон Блокировка вложений молекулы на клетки-хозяина или патогена Спектр действия: ftcornaviruses не сообщалось нет (е г, polouirus, некоторые вирусы простуды) Пути введения: Не одобрено для использования противовирусных FDA Побочные эффекты: Нет Амантадин Ремантадин Нейтрализовать добавить условия, в фаголизосомах, что необходимо для вирусных раздевания Спектр действия: грипп не сообщалось вирус Пути введения: Oral; rimantadne утвержден нет

Antiviral drugs Препараты Описание и принцип действия Клинические проявления Сопротивляемос ть Противовирусные препараты, ингибирующие синтез Ribavirin киназы активируют препарат; ингибируют синтез ДНК и РНК; вирусной ДНК-полимеразы, скорее всего, включают препараты Спектр действия: дыхательная синцитиальный, гепатит С, грипп, корь, некоторые вирусы геморрагической лихорадки нет Пути введения: Oral аэрозоль, IV Побочные эффекты: Может быть вредны для развивающегося плода Аденозин киназы активируют препараты: Спектр действия: Herpewirus Результаты Зависит от










Кейс-ситуация (ВБИ сальм. инфекция карантинные мероприятия, обследование контактных лиц, профилактическое лечение бактериофагами) • Модератор • Начмед по лечебной работе • Заведующий отделением • Лечащий врач, клинический фармаколог (подбор а/б для больного) • Клинический микробиолог (R или S к а/б, МИК) • Медицинская сестра • Врач-бактериолог • Фельдшер-лаборант (методика R-S к а/б) • Зав. баклабораторией • Госпитальный эпидемиолог (результаты смывов) • Специалист эпидотдела Роспотребнадзора ( противоэпидемические мероприятия)

2-Антибиотики.pptx